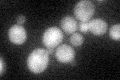
YOR197W
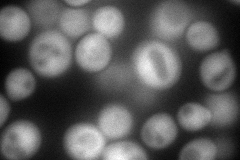
YOR197W
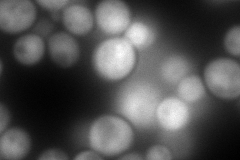
YOR197W
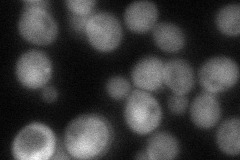
YOR197W
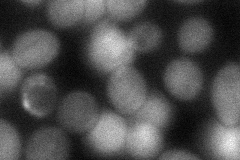
YOR197W
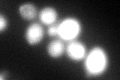
YOR197W
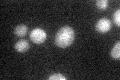
YOR197W

View description
Putative cysteine protease similar to mammalian caspases; involved in regulation of apoptosis upon hydrogen peroxide treatment; proposed to be involved in cell cycle progression
Localization:
Intensity:
Fold change:
Significance:
-
C’ GFP library in SD
cytosol37.96 -
N' NOP1pr-GFP in SD
cytosol148.052 -
N' TEF2pr-mCherry in SD
nucleus244.717 -
N' NATIVEpr-GFP in SD
cytosol69.407 -
N' TEF2pr-VC and Cyto-VN in SD
cytosol61.4888 -
C’ GFP library in SD+DTT
cytosol70.041.84Yes -
C’ GFP library in SD+H2O2

cytosol46.961.23No -
C’ GFP library in Starvation Media
cytosol33.850.89No -
C’ GFP library on the background of Pup2-DaMP

cytosol -
C’ GFP library on the background of CCT mutant

cytosol37.34380.983702No
